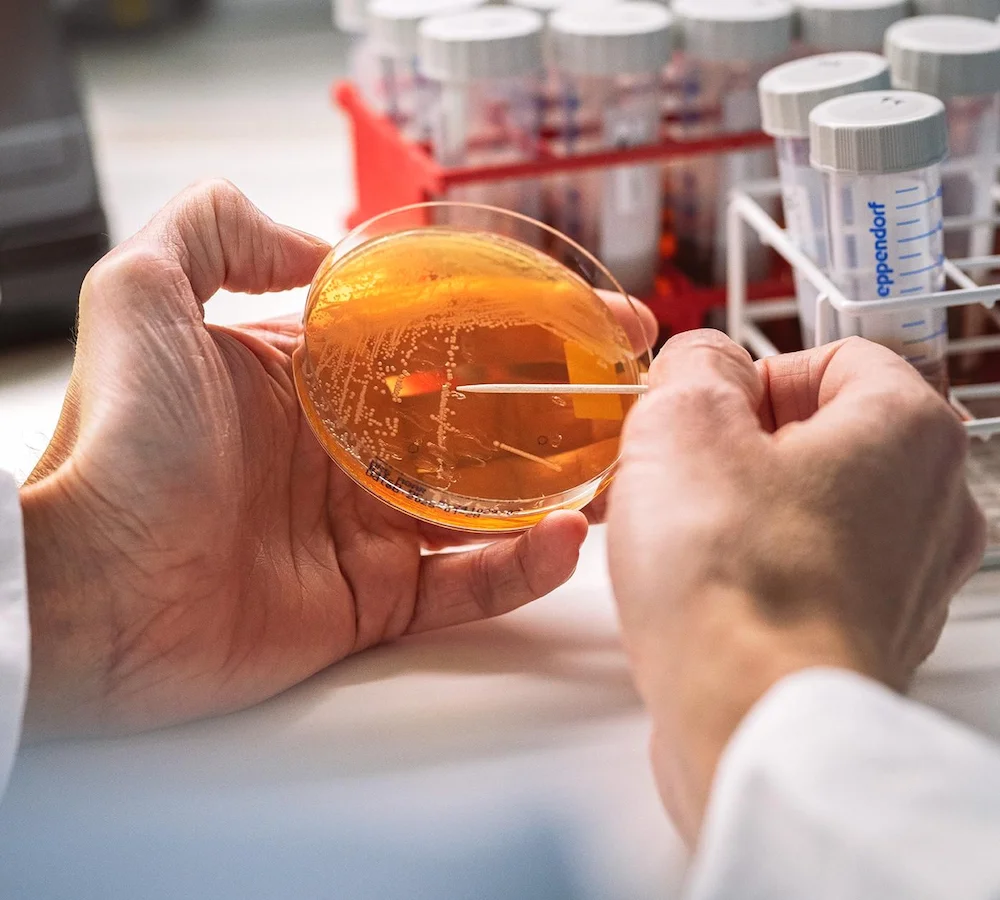
実験される微生物

Novonesisとデンマーク工科大学が提携、ビル・ゲイツも支援するプロジェクトの一環でCO₂の食料転換を進める

デンマークのNovonesisが、ビル&メリンダ・ゲイツ財団とノボ ノルディスク財団が推進する「Acetate Consortium」の一環として、デンマーク工科大学(DTU)と提携し、排気ガスに含まれるCO₂をサステナブルなタンパク質へと変換する取り組みを開始しました。
気候変動の緩和と食料不足の解消に貢献
ガス発酵タンパク質への関心が高まる中、世界最大級のバイオソリューション企業の一つであるNovonesis(Novo Holdingsの子会社)が、公衆衛生と地球環境の両方を向上させる空気由来タンパク質を生産する新たな発酵プロジェクトに着手。
排気ガス由来のCO₂を工業規模でタンパク質に変換する微生物を開発するため、デンマーク工科大学(DTU)のグリーントランジション・バイオテクノロジー研究所(BRIGHT)と提携しました。
この共同研究は、ビル・ゲイツの慈善団体とノボ ノルディスク財団が2023年に立ち上げた「Acetate Consortium」の一環です。イニシアチブ全体では、糖の代わりにCO₂由来の酢酸塩(または酢)を原料とした微生物タンパク質の生産を目指し、3億6,000万デンマーク・クローネ超(約90億円)の資金提供を受けています。
ほとんどの微生物は糖(グルコース)を栄養源として増殖しますが、糖の供給には大量の作物の栽培が必須。これを、回収したCO₂から生成される酢酸塩で置き換えることで、広大な農地の必要性をなくし、気候変動の緩和と食料不足の解消に寄与できると期待されています。
微生物株の改良で収率向上を目指す
バイオテクノロジーを通じてグリーントランジション(環境負荷の少ない持続可能な経済への移行)の加速を目指すBRIGHTは、DTUとノボ ノルディスク財団の研究協力の一環として、今年初めに設立されました。
化石燃料への依存度を低減できる製品の開発によって、デンマークおよび欧州全体のバイオエコノミーを強化することを目的としており、持続可能な素材、クライメイト・ニュートラル(気候中立)な農業のための微生物、そして微生物由来食品の3つを重点分野に据えています。
Novonesisとの共同研究を通じて、BRIGHTの研究チームは、酢酸塩を基質に用いる発酵に適した酵母株を最適化するため、進化工学の技術を応用。プロジェクトでは、微生物の酢酸耐性の向上、代謝速度の加速、タンパク質生産収率の向上、そして発酵時間とコストの削減に焦点を当てます。
BRIGHTのハイスループット自動進化プラットフォームを活用することで、従来であればラボスケールで数年かかる菌株改良を迅速かつ体系的に行えます。
「Acetate Consortium」の第1フェーズ(2023〜25年)では、CO₂を酢酸塩に変換する統合プラットフォームの構築に注力。その後の工程についても、完全に酢酸塩のみを基質として増殖し、40%以上のタンパク質を含む微生物株を創出するところまでは到達しました。
2027年まで続く第2フェーズでは、技術の最適化と規模拡大、食品プロトタイプの開発と試験、そして開発した技術の経済・環境影響のモデル化が行われる予定です。
参考記事:
Novonesis | LinkedIn
Novonesis partners with Technical University of Denmark to scale CO2 protein innovation | The Plant Base
Novonesis & DTU to Convert Carbon Into Protein As Part of Bill Gates-Backed Project
Novonesis and DTU’s BRIGHT join forces to turn captured CO₂ into sustainable protein | PPTI News


この記事へのコメントはありません。